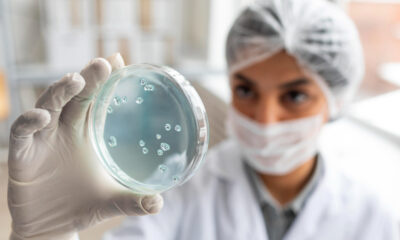
saaudee.com - imagem.pixabay

A relação entre nutrição e câncer é uma área de interesse crescente tanto para profissionais de saúde quanto para pacientes. Uma dieta equilibrada pode ser uma poderosa...



O mundo da pesquisa do câncer está constantemente evoluindo, trazendo novas descobertas e tratamentos inovadores que prometem mudar a forma como encaramos essa doença. Este artigo...



O campo da oncologia está evoluindo rapidamente, trazendo novas esperanças e opções para pacientes com câncer. De imunoterapias revolucionárias a terapias direcionadas precisas, as novidades recentes...

O infectologista é um profissional da área médica especializado no estudo, diagnóstico e tratamento de doenças infecciosas. Sua atuação é fundamental para combater epidemias e pandemias,...
O câncer de mama é o tipo mais comum entre as mulheres no Brasil e no mundo, sendo fundamental disseminar informações sobre medidas preventivas, diagnóstico e...



O Dia Nacional de Combate ao Câncer, celebrado em 27 de novembro no Brasil, é uma ocasião importante para conscientizar sobre a prevenção, tratamento e esforços...